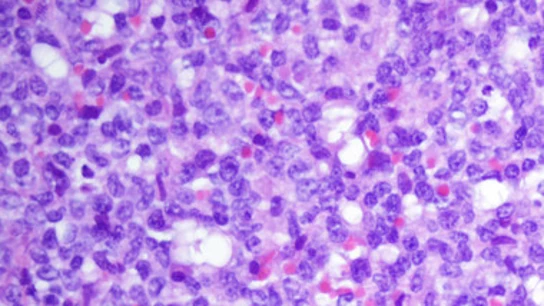

ABRE LAS PUERTAS A NUEVAS TERAPIAS
Descifran cómo funciona el genoma del tipo más frecuente de leucemia
Investigadores del Institut d'Investigacions Biomèdiques August Pi i Sunyer (Idibaps) de Barcelona han descifrado por primera vez el epigenoma completo del tipo de leucemia más frecuente, la leucemia linfática crónica, y han abierto la puerta al desarrollo de nuevas terapias al proporcionar un mapa en alta resolución de sus funciones.
El estudio, publicado en la revista 'Nature Medicine', ha identificado más de 500 nuevas alteraciones en la función del genoma que son específicas de esta leucemia, y comparándola con el mapa de las células sanas, ha revelado las regiones que cambian su funcionalidad, "dianas potenciales para nuevas terapias".
Al comparar, han observado cómo las células de la leucemia son capaces de crear una infraestructura molecular muy eficiente para crecer sin control: "Por así decirlo, donde antes había un desierto, las células de cáncer crean núcleos industriales", ha ejemplificado la primera firmante, Renée Beekman, en un comunicado. A esto se suma el hecho de que han detectado que solo tres familias de proteínas parecen estar encargadas de este cambio, un aspecto importante porque su acción puede ser inhibida con fármacos en desarrollo.
"Quizás este es el aspecto translacional mas importante del estudio, ya que ofrece una perspectiva terapeútica mediante la cual se puedan revertir las alteraciones funcionales en la leucemia", ha valorado el director del Idibaps y coautor del trabajo, Elias Campo, también director de Investigación del Hospital Clínic.
El coordinador del estudio, Iñaki Martin-Subero, ha destacado que han identificado un total de 12 funciones diferentes, tras identificar los genes activos e inactivos y las regiones que, a pesar de no contener genes, controlan su expresión, así como las "zonas oscuras".
El estudio compartirá con otros investigadores esta fuente de información sobre la enfermedad, y se ha realizado dentro del contexto del Consorcio Europeo Blueprint para el estudio del epigenoma y del Consorcio Español del Genoma de la Leucemia Linfática Crónica, y han participado un total de 51 investigadores de 23 instituciones de seis países.
El mismo grupo de investigadores que ha participado en este estudio publicó, hace unos años, la secuencia del genoma y el metiloma de la leucemia, y en este nuevo estudio han avanzado en la caracterización molecular completa de la enfermedad, con técnicas de secuenciación y herramientas de biología computacional.
Para conocer las funciones y su regulación "es necesario el análisis integrador de múltiples capas epigenéticas", y ante el reto del análisis computacional de datos masivos, los científicos han contado con la colaboración del Centro de Supercomputación de Barcelona, ha detallado Martin-Subero, jefe del grupo de investigación en Epigenómica Biomédica del Idibaps.
Una vez generados los datos, el reto se ha centrado en cómo analizar e integrar tantas capas de información, sobre lo que Beekman, ha destacado: "Han sido tres años intensos de análisis informáticos para poder completar el mapa funcional de la leucemia".